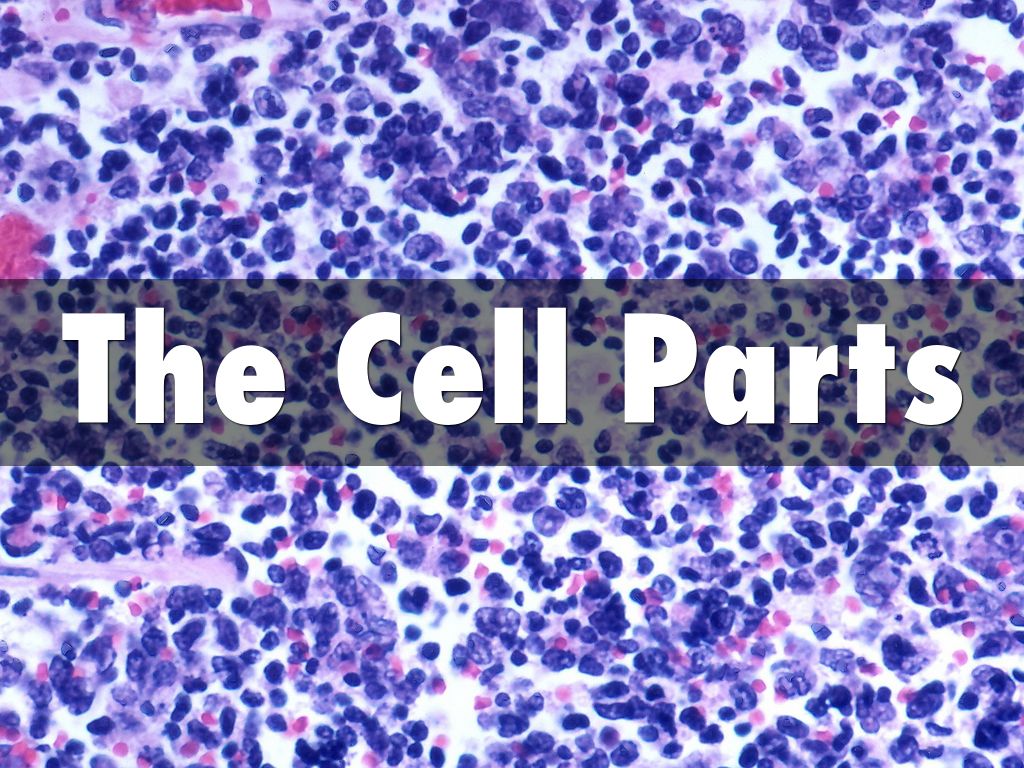
The Cell Parts

Sorry, your browser is not supported. Please update your browser in order to use Haiku Deck.
It looks like you're running an older version of Firefox than we support. Please update to version 23 or later to use the Haiku Deck Web App.
We’re working on adding support for your device -- thanks for your patience!
In the meantime, Haiku Deck is available forChrome orSafari on your Mac or Windows Computer. Or, use Haiku Deck on the iPad.
Your account will be downgraded to Basic at the end of your current billing period.